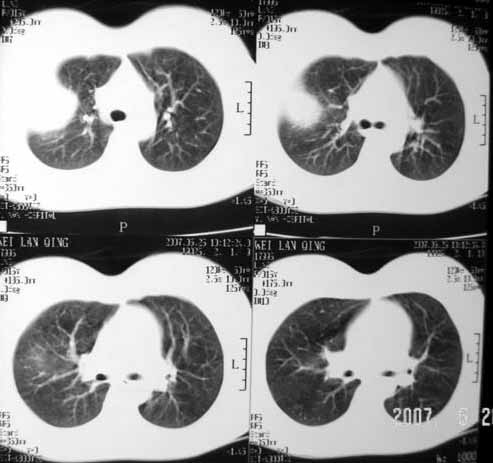

以下是引用dyqct在2007-5-26 12:01:00的发言:[br]右第二肋腋侧呈明显膨胀性、分叶状改变,内无明显间隔,ct值49hu,病变大小约67x57mm,周围硬化缘无断裂,内缘见多数骨嵴,肿块与正常骨间界限清楚。无移行带。周围软组织无浸蚀,胸膜腔无积液。[br]考虑:1、右第二肋动脉瘤样骨囊肿可能性大;[br] 2、需同骨巨细胞瘤、浆细胞瘤、骨纤鉴别。
以下是引用dyqct在2007-5-26 12:01:00的发言:[br]右第二肋腋侧呈明显膨胀性、分叶状改变,内无明显间隔,ct值49hu,病变大小约67x57mm,周围硬化缘无断裂,内缘见多数骨嵴,肿块与正常骨间界限清楚。无移行带。周围软组织无浸蚀,胸膜腔无积液。[br]考虑:1、右第二肋动脉瘤样骨囊肿可能性大;[br] 2、需同骨巨细胞瘤、浆细胞瘤、骨纤鉴别。


以下是引用dyqct在2007-5-26 12:01:00的发言:[br]右第二肋腋侧呈明显膨胀性、分叶状改变,内无明显间隔,ct值49hu,病变大小约67x57mm,周围硬化缘无断裂,内缘见多数骨嵴,肿块与正常骨间界限清楚。无移行带。周围软组织无浸蚀,胸膜腔无积液。[br]考虑:1、右第二肋动脉瘤样骨囊肿可能性大;[br] 2、需同骨巨细胞瘤、浆细胞瘤、骨纤鉴别。
以下是引用dyqct在2007-5-26 12:01:00的发言:[br]右第二肋腋侧呈明显膨胀性、分叶状改变,内无明显间隔,ct值49hu,病变大小约67x57mm,周围硬化缘无断裂,内缘见多数骨嵴,肿块与正常骨间界限清楚。无移行带。周围软组织无浸蚀,胸膜腔无积液。[br]考虑:1、右第二肋动脉瘤样骨囊肿可能性大;[br] 2、需同骨巨细胞瘤、浆细胞瘤、骨纤鉴别。
以下是引用dyqct在2007-5-26 12:01:00的发言:[br]右第二肋腋侧呈明显膨胀性、分叶状改变,内无明显间隔,ct值49hu,病变大小约67x57mm,周围硬化缘无断裂,内缘见多数骨嵴,肿块与正常骨间界限清楚。无移行带。周围软组织无浸蚀,胸膜腔无积液。[br]考虑:1、右第二肋动脉瘤样骨囊肿可能性大;[br] 2、需同骨巨细胞瘤、浆细胞瘤、骨纤鉴别。
以下是引用hhcckk在2007-5-26 14:53:00的发言:[br][br]
[br]病灶定位在肋骨上,原因如图[br]定性支持邓老师的动脉瘤样骨囊肿、骨纤[br]巨细胞瘤较少发生钙化,所以我不考虑[br]桨细胞瘤不会发生膨胀性改变吧,经验少期待老师们的指正[br]骨结核内大多有沙粒状钙化,所以可能性也不大
以下是引用qiuleiyu在2007-5-26 19:50:00的发言:[br]右第二肋腋侧呈明显膨胀性、分叶状改变,内无明显间隔,ct值49hu,病变大小约67x57mm,周围硬化缘无断裂,内缘见多数骨嵴,肿块与正常骨间界限清楚。无移行带。周围软组织无浸蚀,胸膜腔无积液。[br]结合年龄考虑:1、右第二肋动脉瘤样骨囊肿可能性大;[br] 2、需同骨巨细胞瘤、骨纤鉴别。
以下是引用青莲居士在2007-5-26 23:08:00的发言:[br]结核,骨肿瘤良恶性可能都不大.
| 欢迎光临 医影在线 (http://bbs.radida.com/bbs/) | Powered by Discuz! X3.2 |